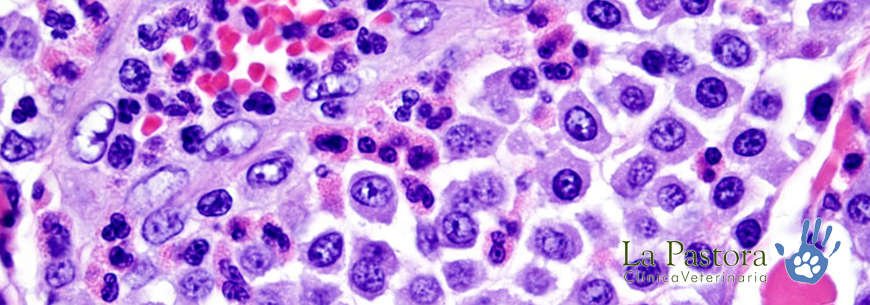

ANATOMIA PATOLOGICA VETERINARIA
Anatomía Patológica Veterinaria es el estudio de las alteraciones estructurales bioquímicas y funcionales en las células, tejidos y órganos que busca explicar los mecanismos por los cuales surgen las señales y síntomas de las enfermedades.
La palabra “patología” significa literalmente “estudio de la enfermedad” y tiene origen en el griego, donde Pathos = enfermedad y Logos = estudio. Sin embargo, patología también se utiliza como sinónimo de enfermedad a secas.
En la medicina veterinaria la patología está dividida en:
PATOLOGÍA GENERAL
Estudio de las reacciones a los estímulos anormales que suceden en todas las células y tejidos
PATOLOGÍA SISTÉMICA O ESPECIAL
Estudio de las reacciones específicas de cada tejido u órgano a determinada afección.
En cuanto a la Patología Clínica, es la especialidad médica responsable por atribuir, identificar y cuantificar la presencia de substancias, células, moléculas y elementos anormales en sangre, orina, heces y en otros líquidos biológicos.
La Anatomía Patológica por su parte es la especialidad médica responsable por atribuir y analizar las alteraciones provocadas por las más variadas enfermedades en las células y tejidos.
Patología Quirúrgica es aquella que analiza especímenes quirúrgicos sólidos buscando la detección de alteraciones en sus células y tejidos.
Y la Citopatología es el análisis de líquidos y secreciones corporales que busca evaluar la presencia de alteraciones celulares.
Algunos de los estudios realizados en Patología Veterinaria son: Análisis Histopatológico, Necropsias y Análisis Toxicológico.













